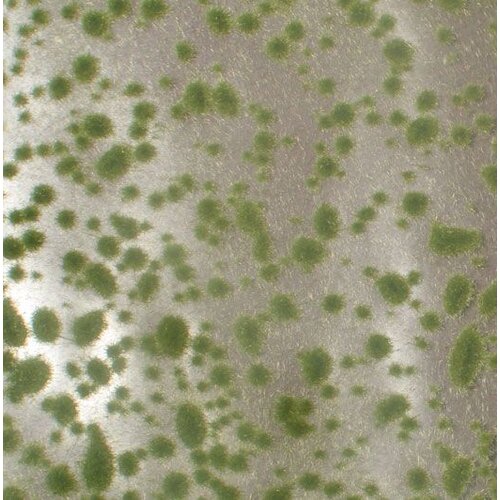
MiniNatur Moss Pads Early Fall 1 : 87 - 747-23 S

U heeft geen artikelen in uw winkelwagen
Moss Pads Early Fall 1 : 87 - 747-23 S
| Artikelcode | 747-23 S |
| EAN | 4048847647237 |
Informatie
MiniNatur Moss Pads Early Fall 1 : 87 (747-23 S) bevat lichtgroene mosstukjes die een sfeervol vroege herfstlandschap of base afmaken. De lichtgroene kleur leent zich perfect voor aangename sfeer. Het kleine 1 : 87 formaat helpt bij het maken van de subtiele details op je base en met een formaat van ca. 15x8 cm kunnen er heel wat bases mee verfraaid worden.
Didn't find what you're looking for?
Laat ons helpen!
Laat ons helpen!
Reviews
average of 0 review(s)
Geen reviews gevonden...